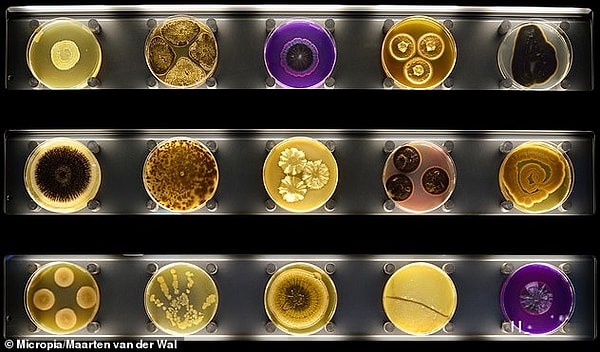

Хотите знать, сколько бактерий обменивается во время поцелуя? В музее, посвященный микробам, есть интерактивный измеритель поцелуев
В человеке содержится около 1,5 килограмма микробов. Тем не менее, большинство людей живут своей жизнью, даже не осознавая, что они там есть. Это то, что музей Artis-Micropia в Амстердаме хочет изменить.
Единственный в своем роде в мире музей посвящен тому, чтобы рассказать миру о микробах и о том, насколько они важны для жизни.

На интерактивной выставке посетители могут узнать, как микробы влияют на то, что вы чувствуете и ощущаете на вкус, болеете ли вы или остаетесь здоровым, и как микробы можно использовать для создания альтернативных источников энергии.
Также в музее можно освежить в памяти историю открытия микробов, узнать о поведении паразитических микробов и о том, как микробы играют роль в ферментации.

Посетители музея также могут принять участие в различных практических занятиях, чтобы узнать больше о том, что называют «самой маленькой и самой успешной из форм жизни».
К ним относятся полное сканирование тела, которое показывает посетителям увидеть, где и в каком количестве микробы находятся на их теле и одежде. Кроме того, есть микроскопы и чашки Петри.
На фото: Поцелуи-о-метр в музее Artis-Micropia в Амстердаме.

Пары тем временем могут проверить измеритель поцелуев, который сообщает партнерам, каким количеством бактерий они обмениваются во время поцелуя.

Artis-Micropia открылся в Амстердаме в 2014 году как новая платная секция Королевского зоопарка Artis Amsterdam. Его цель заключалась в том, чтобы стать больше, чем музеем.
Команда музея объяснила: «Micropia - это не только музей, но и платформа, связующее звено между широкой публикой и наукой.
«Micropia побудит широкую общественность обнаруживать микробы с раннего возраста. Таким образом Micropia повысит имидж микробиологии в нашем обществе, что приведет к увеличению количества студентов, более тесному сотрудничеству со стороны общества в целом и большему количеству инноваций».
Если мысль о посвящении микробам кажется вам немного скучной, вы можете быть удивлены отзывами на Tripadvisor.
Один рецензент написал: «Лучший музей, который я посещал когда-либо», другой назвал его «одним из лучших научных музеев, которые я когда-либо посещал», а другой рецензент сказал: «Поставил бы его под номером 1 в списке для посещения в Амстердаме».
Keşfet ile ziyaret ettiğin tüm kategorileri tek akışta gör!


Напишите комментарий